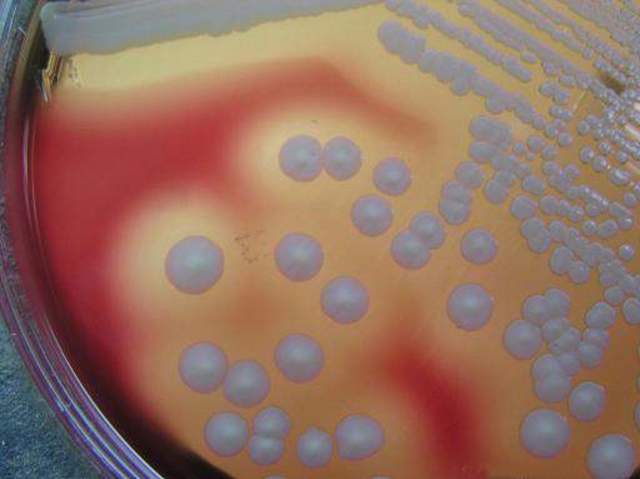
学习体视显微镜采图

-
-
接替菌种库项目,学习口腔常见细菌的分离和鉴定。
感谢肖老师和朱老师。
眼睛也是可以鉴定菌种的。 -
生化鉴定仪对菌种的判断结果准确度有限,受到培养基、菌种活力等影响。鉴定还是测序准确。
-
-
-
-
-
-
-
胞外多糖染色和细菌死活染色
-
数据不好,没有什么变化。
补上初始菌种液的qPCR数据。 -
电镜实验看到三菌种表面物质,估计是多糖类,所以开始加上了多糖方面的实验---黏附力实验、蒽酮实验。
-
序列比对
序列组装
基因预测
聚类与分类
进化树与系统分析 -
蒽酮实验结果不明显,可在实验设计方面改良提高精准度
-
原子力显微镜拍摄,数据处理
-
实验补全计划
生物信息学及相关知识补全计划
Looking for a timeline maker?
Create timelines for projects, roadmaps, history, lessons, legal cases, and stories with Timetoast. Timetoast is a timeline maker for work, school, research, and stories.